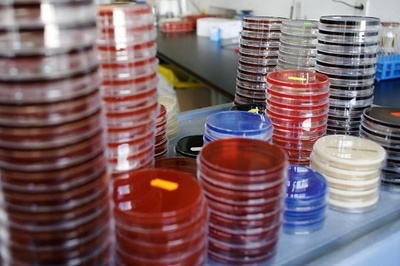
抗生物質が効かない薬剤耐性菌の脅威

抗生物質効かない薬剤耐性菌のまん延、専門家らが警鐘
このニュースをシェア

【1月21日 AFP】抗生物質が存在しない世界では、病気を治癒できずに死亡する人が増え、平均寿命が著しく低下する──。今後、人類はそのような未来を迎える可能性があると研究者らが警鐘を鳴らしている。
薬剤耐性の増加を追跡調査した専門家チームによると、たとえ長年健康であっても、細菌の突然変異によって病気の症状はより重くなり治療費も上がる。さらに死亡のリスクが高まる可能性すらあるという。
専門家の中には、抗生物質の不適切な使用が、世界温暖化やテロ攻撃に匹敵する規模の脅威を健康にもたらしていると指摘する者もいる。ただ薬剤耐性のまん延は完全に予防することができる。
仏パスツール研究所(Pasteur Institute)で抗生物質の研究チームを率いるパトリス・クルバラン(Patrice Courvalin)氏は、「病気の治療が不可能になるということだけでなく、この20年~30年間の進歩が台無しにすらなりかねない」と指摘する。
重篤患者に特定のリスクをもたらす日和見感染細菌に対して有効な抗生物質がなければ、大きな手術、臓器移植、がんや白血病の治療ができなくなる可能性があるという。